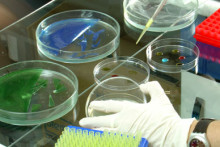

Estudiantes de Bioquímica preparan jornada científica con niños de escuelas vulnerables
Con esta actividad, los estudiantes de la Facultad de Química y Biología, se suman a la celebración del trigésimo aniversario de la Asociación Nacional que los agrupa (ANEB). Eligieron el Colegio Forjadores de Peñaflor donde realizarán la feria “Ciencia en tus manos”.